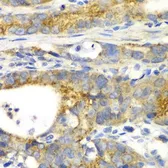
Anti-GRASP65 antibody used in IHC (Paraffin sections) (IHC-P). GTX32631

5 Search results for
NP_114105
Product
Images
Description
Applications
Reactivity
Price
-
$519100μl
-
$519100μl
-
$519100μl
-
Description Rabbit PolyclonalApplications WBReactivity Hu$419100μl$16925μl
-
$419100μl
 Overexpression
Overexpression
![Anti-GRASP65 antibody [5G8] used in IHC (Paraffin sections) (IHC-P). GTX84424 Anti-GRASP65 antibody [5G8] used in IHC (Paraffin sections) (IHC-P). GTX84424](/upload/website/prouct_img/small/GTX84424/GTX84424_2702_IHC-P_w_23061420_785.webp)
![Anti-GRASP65 antibody [5C5] used in Immunocytochemistry/ Immunofluorescence (ICC/IF). GTX84423 Anti-GRASP65 antibody [5C5] used in Immunocytochemistry/ Immunofluorescence (ICC/IF). GTX84423](/upload/website/prouct_img/small/GTX84423/GTX84423_1077_ICCIF_w_23061420_369.webp)
![Anti-GRASP65 antibody [4F8] used in Immunocytochemistry/ Immunofluorescence (ICC/IF). GTX84422 Anti-GRASP65 antibody [4F8] used in Immunocytochemistry/ Immunofluorescence (ICC/IF). GTX84422](/upload/website/prouct_img/small/GTX84422/GTX84422_1076_ICCIF_w_23061420_126.webp)